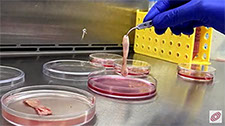

Apresentação da Dissertação “Canabigerol reduz a hiperalgesia aguda e crônica em animais submetidos à hipóxia-isquemia
pré-natal" de Bismarck Rezende

A obesidade já é considerada um dos principais problemas de saúde pública no mundo. As consequências aparecem nos índices crescentes de diabetes, hipertensão, câncer. O prof. da FCM da UERJ, Luiz Guilherme Kraemer de Aguiar, é o convidado deste episódio do Em Questão sobre obesidade.
Plataforma Sucupira
Acesso a Produção Científica
Programa de Pós-graduação em Fisiopatologia Clínica e Experimental
Blvd. 28 de setembro, nº 77, Prédio do CePeM, 2º andar, Sala do FISCLINEX
Rio de Janeiro/RJ - Brasil CEP: 20551-030
Tel.: 2868-8212/2868-8215/2868-8230 - RAMAL 106
Email: - posclinex.uerj@gmail.com